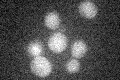
YDR316W
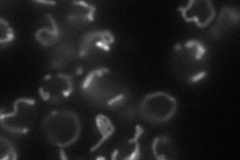
YDR316W
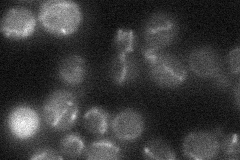
YDR316W
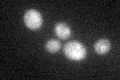
YDR316W

View description
Protein integral to the mitochondrial membrane; has a conserved methyltransferase motif; multicopy suppressor of respiratory defects caused by OXA1 mutations
Localization:
Intensity:
Fold change:
Significance:
-
C’ GFP library in SD
below threshold16.71 -
N' NOP1pr-GFP in SD
mitochondria55.2423 -
N' TEF2pr-mCherry in SD

mitochondria24.865 -
N' NATIVEpr-GFP in SD
mitochondria18.4146 -
N' TEF2pr-VC and Cyto-VN in SD

#N/A0 -
C’ GFP library in SD+DTT
cytosol16.821No -
C’ GFP library in SD+H2O2

cytosol17.081.02No -
C’ GFP library in Starvation Media

cytosol15.220.91No -
C’ GFP library on the background of Pup2-DaMP

N/A -
C’ GFP library on the background of CCT mutant

N/A0N/AYes
